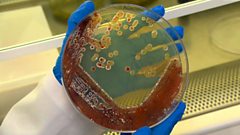

Main content

The Technology Powering Protest
Danny Vincent looks at how technology is used by protesters in Hong Kong. Click also investigates if tech can make the fashion industry more sustainable.
Last on
Fri 4 Oct 201900:30GMT
BBC News Latin America & North America only
More episodes
Clips
![]()
The new high-tech way to recycle old clothes
Duration: 01:27
![]()
Will virtual clothes transform how we shop?
Duration: 01:30
![]()
How Hong Kong protesters avoid police surveillance
Duration: 01:37
![]()
How bacteria could make fashion more eco-friendly
Duration: 01:34
Credit
| Role | Contributor |
|---|---|
| Presenter | David Vincent |
Broadcasts
- Sat 14 Sep 201900:30GMTBBC News except UK & UK HD
- Sat 14 Sep 201906:30GMTBBC News except UK & UK HD
- Sat 14 Sep 201919:30GMTBBC News except UK & UK HD
- Sun 15 Sep 201903:30GMTBBC News except UK & UK HD
- Sun 15 Sep 201913:30GMTBBC News except UK & UK HD
- Thu 19 Sep 201900:30GMTBBC News Latin America & North America only
- Thu 19 Sep 201908:00GMTBBC News except UK & UK HD
- Tue 24 Sep 201900:30GMTBBC News Latin America & North America only
- Wed 2 Oct 201900:30GMTBBC News Latin America & North America only
- Fri 4 Oct 201900:30GMTBBC News Latin America & North America only